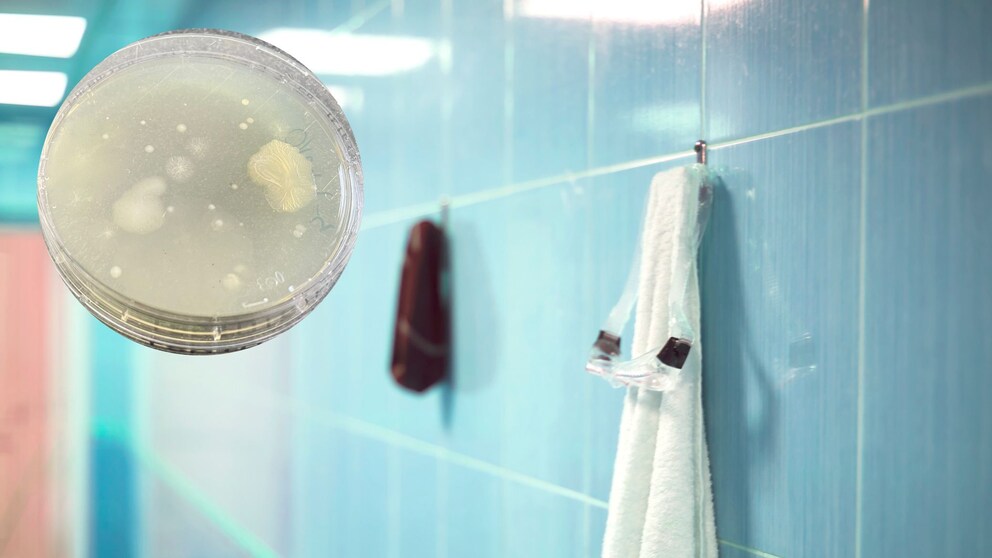

July 3, 2023, 12:54 pm | Read time: 6 minutes
With their indoor and outdoor pools and water slides, Germany’s adventure pools are a popular year-round destination. The pool water is chlorinated everywhere. But what about hygiene in other areas of the pools? TRAVELBOOK wanted to know and took germ samples at various locations in five of Germany’s most popular adventure pools. Alarming: In four of the five pools, fecal germs were found in the showers, with two showing significantly elevated levels. The full analysis and what experts say: TRAVELBOOK provides an overview.
Have you ever been to an adventure pool? Then you surely know how many people gather there in a relatively small space. Numerous visitors can be found in changing rooms and showers, at loungers, and attractions. Perhaps you’ve also wondered about hygiene under these circumstances. There are no figures or studies on this yet. That’s why TRAVELBOOK took random samples to see how many germs lurk in various places in large German adventure pools–with partly alarming results.
How was the investigation conducted?
In five of Germany’s largest and most popular adventure pools, TRAVELBOOK randomly tested for germs and enterobacteria (bacteria of the intestinal flora), explicitly including Escherichia coli (E. coli), which can cause infectious diseases. To determine the contamination with enterobacteria, TRAVELBOOK used contact plates with nutrient media. For each sample, the plates were pressed with the nutrient surface onto the area to be examined, then sealed and labeled. The areas examined were the floor of the women’s shower, the locker wristband, the handle in the changing room, and the armrest of a lounger. The samples were taken during regular pool operations.
They were then sent for analysis to MykoLab Kaldorf GmbH. The laboratory in Mönchengladbach specializes in the microbiological examination of samples for mold and bacteria from indoor areas. In the lab, the nutrient media were incubated, and the bacterial colonies (colony-forming units, CFU) were identified and counted. The rule is: All samples with values over 100 CFU per contact sample are rated as “unacceptable contamination with fecal germs.”
Fecal germs in the showers of almost all examined adventure pools
According to the lab analysis, fecal germs were detected in four of the five samples from the floors of the women’s showers. Alarming: “In two samples, the concentrations were so high that I would speak of a significant hygiene deficiency,” says Dr. Michael Kaldorf, CEO of MykoLab Kaldorf GmbH. One of the affected samples showed a value of more than 100 CFU for general enterobacteria, representing unacceptable contamination with fecal germs. In the other sample, the total number of enterobacteria was lower (50). However, the detectable Escherichia coli count was very high at about 450.
On a positive note, according to Dr. Michael Kaldorf, no fecal germs were found at the other examined locations such as the armrest of the lounger, wristband, and changing room in any of the five randomly tested pools.
How serious is the fecal germ contamination in the showers?
Fecal germs in the shower may be gross–but do they pose a health risk to bathers? TRAVELBOOK asked Matthias Riedl, a specialist in internal medicine, for his assessment. “Wherever there are people, there are also their fecal germs. They get on hands through incomplete hygiene during bowel movements,” Riedl explains. However, he reassures: “The fecal germs on the floor usually do not end up in our mouths, so the floor contamination is harmless.”
Dirk Bockmühl, professor of hygiene and microbiology at the Rhine-Waal University of Applied Sciences, confirms this. “In fact, the presence of fecal germs on the floor is not too big a problem because a direct infection route is missing, as these bacteria must be ingested–usually in quite high numbers–through the mouth to cause illness. However, pool operators must ensure through reasonable hygiene and cleaning measures that their numbers never rise to a health-threatening level.”
Although fecal germs on the floor of a swimming pool shower do not necessarily pose a health risk according to experts, they should not be detectable at all. Dr. Michael Kaldorf explains this by referring to the “Guideline of the German Society for Bathing” (Deutsche Gesellschaft für das Badewesen e.V.). “From this, it can be deduced that the hygiene condition in pools can only be considered completely satisfactory if fecal germs are not detectable. In my opinion, any value over 100 CFU per contact sample indicates an unacceptable level of fecal contamination.”
Have you ever wondered where germs and pests lurk in hotel rooms? Find out more

Beach on Tenerife Closed Due to Fecal Bacteria

According to Research: This Is the Dirtiest Item in Your Luggage
How serious is the fecal germ contamination?
The hygiene standards for public swimming pools are outlined in the recommendation “Hygiene Requirements for Pools and Their Monitoring.” The health departments of the respective federal states where the swimming pool is located are responsible for checking whether a pool operator actually complies with these hygiene standards. “The health department’s inspections serve to verify compliance with microbiological and physicochemical requirements for swimming and bathing pool water,” says Pascal Murmann from the Baden-Württemberg health department. “The health departments also inspect other areas during these checks, such as barefoot areas, seating areas, and sanitary facilities.”
“A pool operator must ensure that any health risks to humans due to non-compliance with the requirements are excluded,” explains Murmann. “If deficiencies are identified or risks to human health are apparent due to non-compliance with the requirements, action must be taken.”
“Concerning” levels of fecal germs on restaurant tables
In addition to fecal germs, TRAVELBOOK’s analysis found high levels of germs on restaurant tables in two of the examined adventure pools. “If you compare these results to studies on the hygiene status of public restrooms, the results are not necessarily alarming,” says Kaldorf. “However, the fact that high germ counts were found on restaurant tables in two pools is concerning. While restaurant tables are not food preparation surfaces, they still should not be heavily contaminated.”
TRAVELBOOK reached out to the health departments of the respective federal states for a statement on whether swimming pool operators are actually adhering to these hygiene standards, but had not received a response by the time of publication.